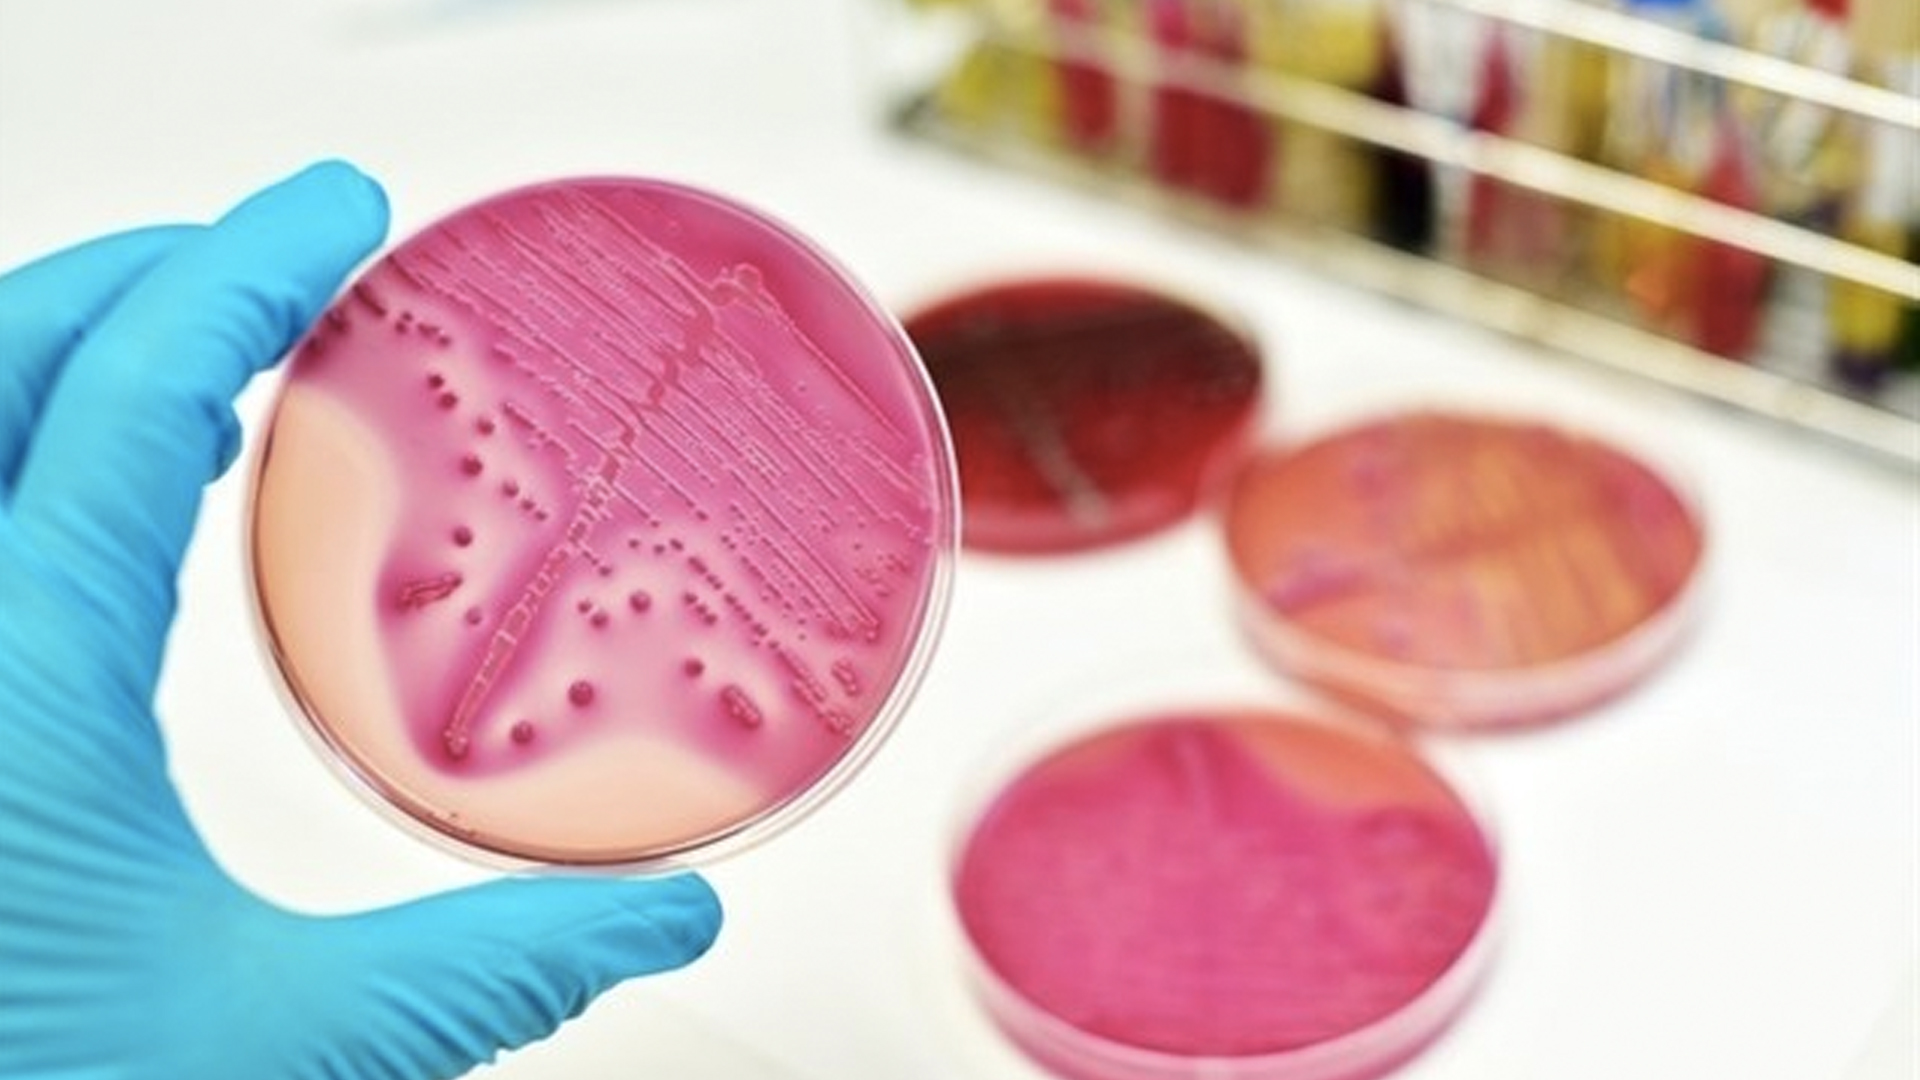
Aumentan casos de cáncer en Europa pero disminuyen las muertes - enfermedades

La OMS indicó que 2.4 por ciento de la población estaba afectada de cáncer en 2014, una proporción que aumentó un 50 por ciento desde 2000
El número de casos de cáncer en Europa sigue aumentando con regularidad, pero la mortalidad ligada a este enfermedad está en constante caída, subraya la Organización Mundial de la Salud en su “Informe sobre la salud en Europa” publicado el miércoles.
En la “región Europa”, que para la OMS cubre 53 países que van de Portugal a Rusia pasando por Kirguistán, 2.4 por ciento de la población estaba afectada de cáncer en 2014, una proporción que aumentó un 50 por ciento desde 2000.
Esta cifra oculta sin embargo grandes disparidades según el tipo de cáncer y las poblaciones que se toman en consideración.

Así, en los países nórdicos -Suecia, Noruega, Finlandia, Dinamarca, Islandia- la prevalencia es dos veces mayor (5 por ciento), mientras que se reduce (1.8 por ciento) en la Comunidad de Estados Independientes (CEI), que agrupa a nueve países del antiguo bloque comunista, incluidos Bielorrusia, Georgia o Rusia.
La tasa se elevaba a 2.8 por ciento en la Unión Europea en 2013, ligeramente superior en el caso de las mujeres (2.9 por ciento) que de los hombres (2.7 por ciento).
La fuerte incidencia del cáncer en los países nórdicos muestra “el éxito” de su programa de detección, considera Claudia Stein, directora de información e investigación de la OMS. “Identifican ciertos tipos de cáncer mucho antes de que aparezcan los síntomas, lo que por supuesto favorece su tratamiento, pero infla las cifras”, explicó a la AFP.
En toda la región, la incidencia del cáncer de mama aumentó un 30 por ciento desde 2000 para estabilizarse en 110 nuevos casos por año por 100 mil mujeres en 2014. Aunque la evolución es homogénea en toda Europa, en los países nórdicos se diagnostican más cánceres de mama: 175 nuevos casos 100 mil mujeres en 2014.
El cáncer de mama es más frecuente, pero también se trata mejor. La mortalidad ligada a esta enfermedad disminuye con regularidad desde finales de los años 1990, estableciéndose en 20 muertes por 100 mil mujeres en 2015, frente a 23.8 en 2000. La mortalidad es inferior en los países nórdicos que en el conjunto de la Unión Europea (18.3 muertes por 100 mil mujeres en 2015 frente a 21.4).
También el cáncer del cuello del útero registra una evolución diferente según los países: el número de nuevos casos sigue bajando lentamente en la UE (12 por 100 mil mujeres en 2014, -12.5 por ciento desde 2000), mientras que aumenta en el caso de la CEI (17.8 nuevos casos por 100 mil, +23 por ciento desde 2000).
Los fallecimientos por esta dolencia caen constantemente desde los años 1970 en la UE (3 fallecimientos por 100 mil en 2015), mientras en la CEI son dos veces más (6.9 fallecimientos por 100 mil en 2014).
Los cánceres de traquea, bronquios y pulmón se establecieron en el conjunto de la “región Europa” en 49 casos por 100 mil habitantes en 2014 y su mortalidad disminuye una media de -13 por ciento desde el año 2000, aunque aumentó 10 por ciento en el caso de Portugal.